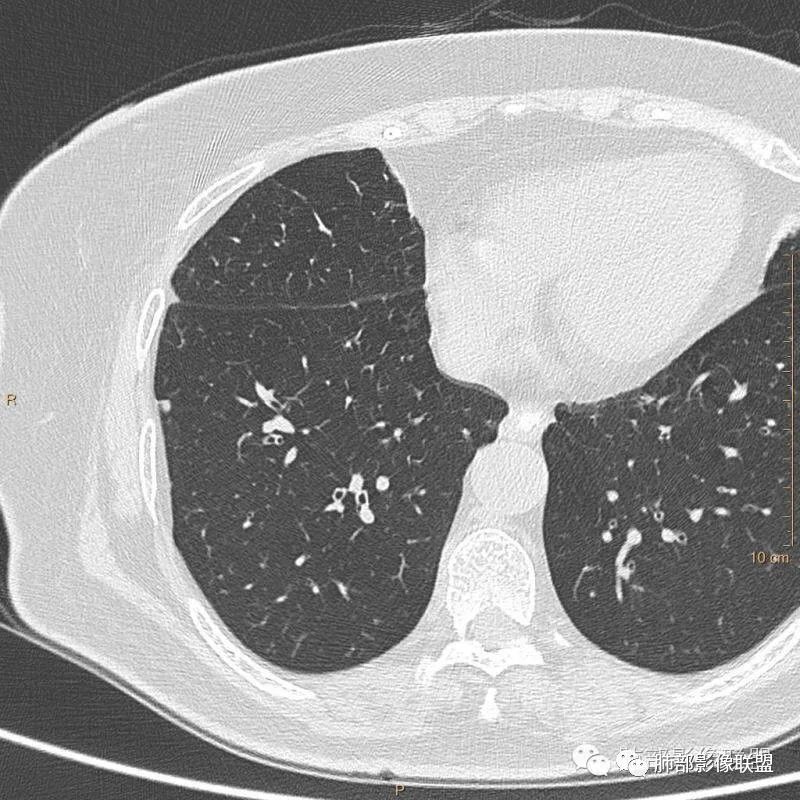
【病例】肺内淋巴结7例CT影像诊断要点-2

肺内淋巴结7例CT影像诊断要点
发布时间:2022-12-01
发布时间:2022-12-01
病例展示
病例一:

病例二:

病例三:


病例四:


病例五:

病例六:


病例七:

病例分析
以上病例,有什么共同点?1、病灶均位于胸膜下或叶间胸膜下;
2、病灶边缘多平直,大部分呈三角形,部分呈椭圆形;
3、病灶边缘见一条或数条细线与胸膜相连。
如图所示:







答案:
以上病例均为肺内淋巴结。您诊断对了吗?
没诊断对也没关系,我们一起来学习肺部影像联盟黄勇教授教给我们的秘诀
肺内淋巴结诊断要点总结
正常情况下,肺内淋巴结是不显示的,一般是慢性炎症所致,老年人和吸烟者多见。影像上常见于胸膜或叶间胸膜下,迄今为止,所有的报道均距胸膜或叶间胸膜小于2.0cm以内。也可以表现为与胸膜或叶间胸膜相贴的结节。绝大多数位于中下叶(气管隆突水平以下),上叶也可见到,但较少见。
长径均小于12mm。典型的形状为三角形,也可以为梭形、圆形或椭圆形。诊断的关键在于见到1-5条细线与胸膜、叶间胸膜或静脉相连,有时状如坐落于电路板的“二极管”,但以薄层CT显示为佳。有作者病理对照线状影为小叶间隔,有作者病理对照为淋巴管。其实不矛盾,因为淋巴管走行于小叶间隔内。
需要与小肺癌、肺转移瘤进行鉴别。肺内淋巴结除细线状影外,边缘清晰无分叶,无毛刺,没有磨玻璃晕,少张力等是与肺癌鉴别的关键。有作者对9例胸膜下的小于1cm的肺转移瘤进行对照,后者均为较为游离的类圆形,无线状影与胸膜或肺静脉相连。
对怀疑肺内淋巴结的病例,必须行薄层扫描,推荐1.5mm及以下层厚。因为在5mm层厚图像,肺内淋巴结可以由于部分容积效应表现为磨玻璃密度结节,而且对线状影及病变形状的显示也欠清晰。
诊断肺内淋巴结最关键指出在于薄层扫描见到细线状影与胸膜、叶间胸膜及肺静脉相连。
上一篇:气管腺样囊性癌1例CT影像
下一篇:胸部钙化临床意义和疾病谱